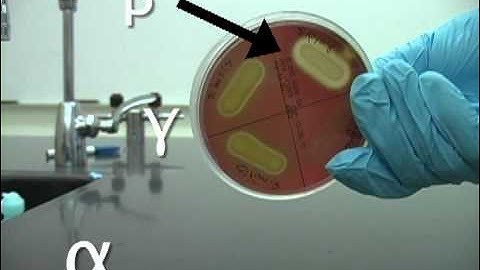
Identifying hemolysis.

⬇ DOWNLOAD NOW
Kalau muncul iklan pop-up, tutup lalu klik tombol kembali
Download lagu Blood Agar and Hemolysis: Alpha, Beta & Gamma with Bacterial Examples secara gratis hanya untuk keperluan promosi. Dukung artis favorit kamu dengan membeli musik original di iTunes atau platform resmi lainnya.
 Microbiology: Hemolysis/Blood Agar
Microbiology: Hemolysis/Blood Agar
 Beta Hemolysis on Blood Agar
Beta Hemolysis on Blood Agar
 Microbiology - Hemolysis
Microbiology - Hemolysis
 Comparison of hemolysis on blood agar.mov
Comparison of hemolysis on blood agar.mov
 Types of Hemolysis by Bacteria | Alpha Beta and Gamma Hemolysis Detection | Basic Science Series
Types of Hemolysis by Bacteria | Alpha Beta and Gamma Hemolysis Detection | Basic Science Series
 Haemolysis reaction, alpha, beta and gama hemolysis
Haemolysis reaction, alpha, beta and gama hemolysis
Identifying hemolysis.
Identifying hemolysis.
 Microbiology: Beta hemolysis, α-hemolysis, γ-hemolysis
Microbiology: Beta hemolysis, α-hemolysis, γ-hemolysis